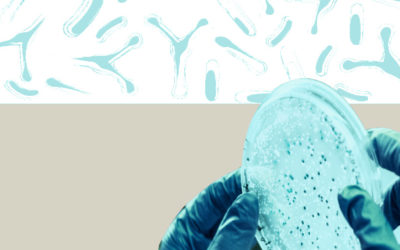
HMBbanner

Humans & the Microbiome
How do microbes that live in and on us affect our health, development and even behaviour?
Micro-organisms cover our skin and fill our guts. These bacteria, viruses, and fungi — collectively called the human microbiome — have significant impact on human health. This program brings together anthropologists, biologists, and other scholars to address questions about the microbiome’s impact on human health and development, and how it is affected by individual and societal behaviour.
IMPACT CLUSTERS
The Humans & the Microbiome program is part of the following CIFAR Impact Clusters: Nurturing a Resilient Earth and Shaping the Future of Human Health . CIFAR’s research programs are organized into 5 distinct Impact Clusters that address significant global issues and are committed to fostering an environment in which breakthroughs emerge.
RESEARCH AND SOCIETAL IMPACT HIGHLIGHTS
Tracking perception of the human microbiome
Through ethnographic and semi-structured interviews with adults in the United States,
CIFAR program Fellow Melissa Melby (University of Delaware) and Advisor Mark Nichter (University of Arizona) found public perception of the human microbiome centres on gut microbiome only, whereas the microbial populations of the skin, lungs and many other areas are also critically important. These findings will help inform how best to shape information about the microbiome for the public, and identify areas of further research needed.
UNDERSTANDING MILK MICROBIOME VARIATION IN BREASTMILK
Through a CIFAR Catalyst Fund project, Fellows Meghan Azad (University of Manitoba, Children’s Hospital Research Institute of Manitoba) and Naama Geva-Zatorsky (Technion - Israel University of Technology) are discovering how indoor and outdoor environmental factors affect the composition of the milk microbiome. The outcomes of this project could have far-reaching implications on the habits and recommended behaviour of families, especially before delivery, and during the first months of infants’ lives as mothers’ milk affects their infants’ gut.
Path to Societal Impact
We invite experts in industry, civil society, healthcare and government to join fellows in our Humans & the Microbiome program for in-depth, cross-sectoral conversations that drive change and innovation.
Leaders from public health schools and CIFAR fellows in the Humans & the Microbiome program are working together to develop new public health curricula.
Areas of focus:
- Integrating emerging evidence from microbiome research into health systems
- Developing microbiome-based public health curriculum materials that enhance public health messages
Founded
2014, 2026
Renewal Dates
2020
Interdisciplinary Collaboration
Microbiology
Developmental, evolutionary and stem cell biology
Bacteriology
Immunology
Anthropology
Biochemistry
Public Health
History
Neuroscience
Philosophy
CIFAR Contact